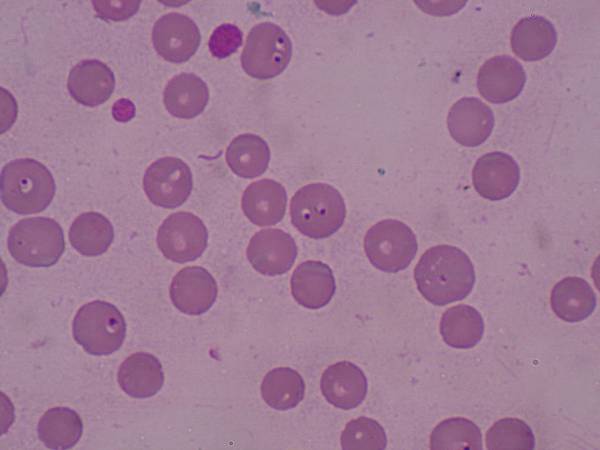
Capture_00008

又進入秋冬季節,此季節為壁虱大量生長的季節,當帶寵物
去郊外踏青時,需要小心壁虱的感染,並且更要注意因壁虱傳染
的血液寄生蟲疾病「犬焦蟲症」,犬焦蟲感染症是一種血液原蟲
感染,造成紅血球破裂,引起溶血性貧血,造成動物死亡。常見
的犬焦蟲種類有兩種,分別為Babedia canis(俗稱:犬大焦蟲)
與Babesia gibsoni(俗稱:犬小焦蟲),皆會引起嚴重且致命的
疾病。

B. canis 在血液抹片下的型態
B. gibsoni 在血液抹片下的型態
致病機轉
當帶有焦蟲病原體的壁虱叮咬到狗時,經由其唾液將焦蟲病
原體釋放至動物體內,感染紅血球,引起溶血性疾病,當大量溶
血時,會釋放出內原性致熱原,引起動物發燒,並且因為溶血產
生黃疸、膽紅素尿,而大量的溶血引起紅血球的不足,無法攜帶
足夠的氧氣供應體內組織的需求,引發組織缺氧、細胞壞死,最
終造成多重器官衰竭,產生休克、死亡。
常見的臨床症狀
焦蟲症的感染可以區分為急性與慢性,急性感染會引起厭食、
發燒、昏睡,產生急性溶血性貧血、脾腫大與血小板減少症,血
尿與黃疸也是常見的臨床症狀之一。臨床上B. gibsoni感染會引
起較嚴重的臨床表徵,其致死率較B. canis感染高。而慢性的感
染通常無明顯的臨床症狀,感染的動物會變成隱性的帶原者。
臨床診斷
1.理學檢查:動物會出現黏膜蒼白、精神差、食慾下降與發燒等
臨床表徵。
2.血液檢查:因為焦蟲會破壞紅血球,造成紅血球數量與血容比
降低,而通常會呈現大球性再生性貧血反應,當大量感染時,紅
血球內會出現焦蟲的病原體,如在血液抹片中有看到病原體即可
確定為焦蟲感染,而紅血球的型態也會產生異常,出現大量未成
熟的紅血球。
3.PCR診斷:如血液抹片無發現病原體,但又極度懷疑為焦蟲感
染,需要抽血送往專業的實驗室,進行核酸分析,以確定焦蟲感
染。
治療
當確定為焦蟲感染時,需要區別是B. canis或B. gibsoni感
染,因為兩者對於藥物的反應不盡相同,而治療的目的為減低體
內原蟲的數量,解除因焦蟲感染引起的臨床表徵,使動物恢復正
常的精神食慾,經過特定的藥物治療後,只有少數的動物是可以
完全清除體內的病原,大部分的治療結果都是體內的免疫能力與
病原體形成一個平衡狀態,無法完全清除病原。
1.B. canis感染:目前常用的治療藥物為Imidocarb dipropio
-nate與Diminazene aceturate,文獻指出這兩種藥物對於殺
滅B. canis的病原皆有良好的效果,缺點是其副作用較高,容易
引起注射部位的疼痛與腫脹,嘔吐或神經症狀。
2.B. gibsoni感染:上述的兩種藥物殺滅B. gibsoni的效果比殺
滅B. canis差,而目前較佳的治療藥物為Azithromycin與Atova
-quone的合併使用,也較無副作用,缺點為此類的藥物非常昂貴。
3.輸血:當動物嚴重貧血,出現心搏過快、呼吸急促、虛弱與昏厥
等臨床表徵時,造成生命受到威脅時,需要緊急輸血以減緩臨床症
狀。臨床上常用血容比來判定其貧血的嚴重程度,但還是需要配
合其臨床表徵,才能決定輸血適當的時機。
4.輔助治療:除了給予殺滅病原的藥物外,也需要給予其他輔助的
藥物或營養,治療其因焦蟲感染引發的臨床症狀,給予血液製造所
需要的養分,改善貧血的臨床症狀。
預防
1.避免壁虱的叮咬:壁虱感染是目前傳播焦蟲病原的最大因子,
定期的使用除外寄生蟲藥物,降低壁虱叮咬的機會,是預防此疾
病的最佳方式。
2.避免因輸血而造成感染:輸血也是焦蟲傳染的一種途徑,當
動物需要輸血時,捐血狗必須經過血清學的檢查,確定為無焦
蟲感染的個體,才能避免因為輸血而造成焦蟲的感染。
焦蟲症也是新興的人畜共通傳染病之一,當帶有焦蟲病原的
壁虱叮咬到人類時,人類也會感染焦蟲,大部分都沒有臨床症狀,
但也有少數的病患會產生嚴重的臨床症狀,甚至死亡,當家中有
年老或免疫力較差的家人時,更需要長期使用外寄生蟲預防藥物,
避免壁虱的感染,才能預防疾病的發生。
請先 登入 以發表留言。